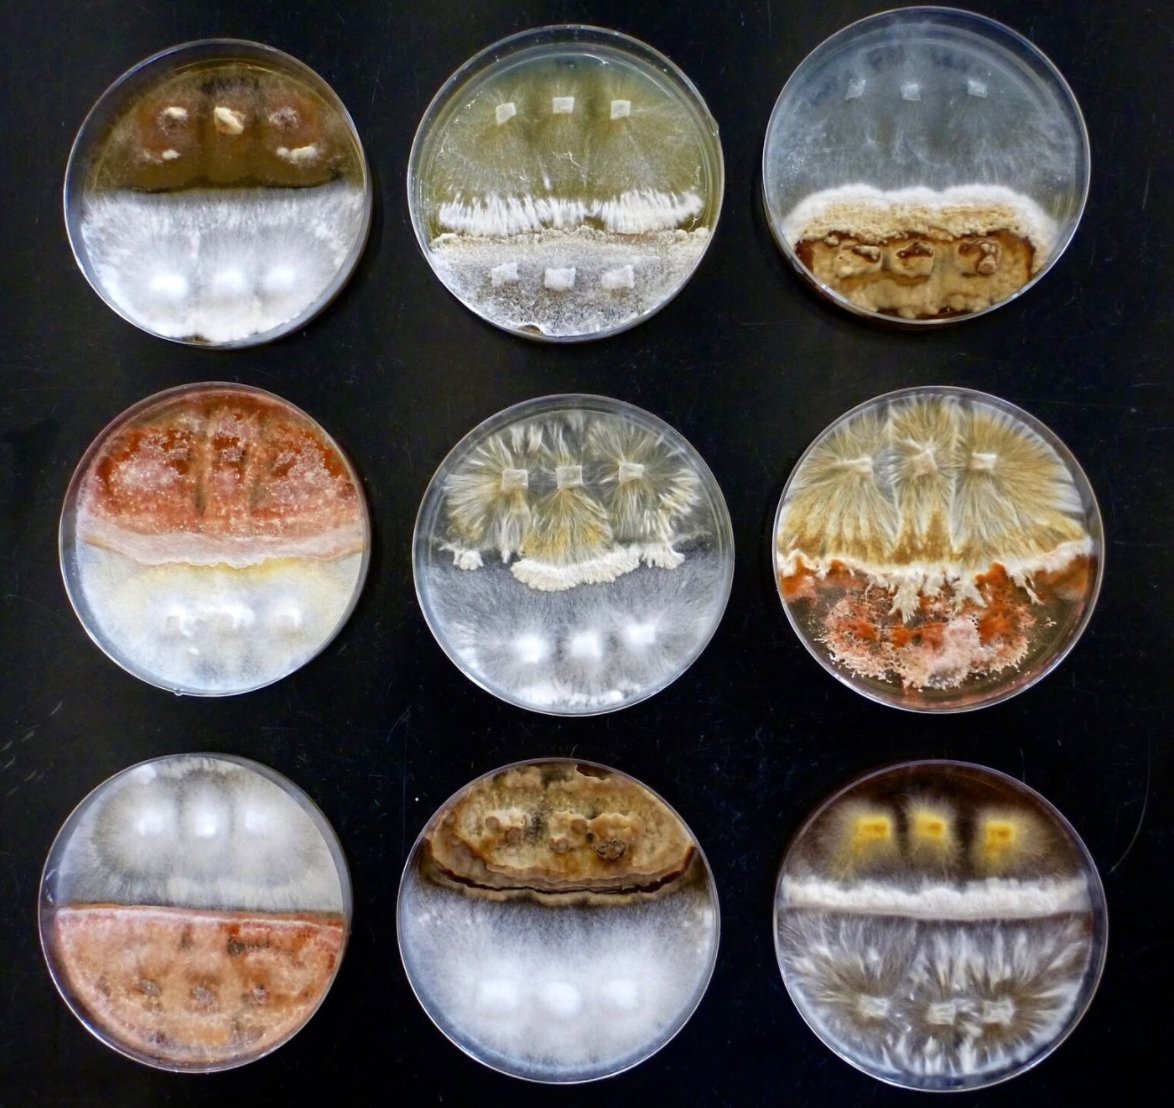
Crowther Lab tweet media

MRes BIOSI Cardiff U retweetledi
MRes BIOSI Cardiff U
1.9K posts

MRes BIOSI Cardiff U
@MResBIOSI
Cardiff University MRes Biosciences / Prifysgol Caerdydd MRes Biowyddorau
Sir Martin Evans Building Katılım Eylül 2014
48 Takip Edilen189 Takipçiler
MRes BIOSI Cardiff U retweetledi

Llongyfarchiadau! Pob dymuniad da! Many congratulations @JordanCuff and Bhavana Gupta - very much appreciated you calling-by the office @CUBiosciences after the wedding. First ever @MResBIOSI nuptials and @c4news - a day to remember in so many ways! @CUBiosciences @cardiffuni
Andy Davies@adavies4
‘A short, sharp shock to turn back the clock’ Wales to enter ‘fire-break’ lockdown From Cardiff, our #c4news report (with thanks for opening sequence & many congratulations to @JordanCuff & Bhavana Gupta!) [Team @c4marcus @daibaker & Kevin Langdon] channel4.com/news/wales-to-…
English
MRes BIOSI Cardiff U retweetledi

Llongyfarchiadau 🎉
We’d like to say a huge congratulations to Bhavana, post-doc at @CUCancerInst & Jordan Cuff, from @CUBiosciences who tied the knot!
Their wedding day story touched many hearts yesterday and we all hope you enjoyed your big day.
standard.co.uk/news/health/gr…
English
MRes BIOSI Cardiff U retweetledi

My #FavouriteBee for #WorldBeeDay - Anthophora alluaudi, a Canary Island endemic that's one of the most abundant and important pollinators on Tenerife. We've studied it since 2003 and, despite its abundance, have found precisely one nesting site for this enigmatic species.

English
MRes BIOSI Cardiff U retweetledi

Lockdown has dramatically cut carbon emissions - but it won't be enough to slow down climate change, say researchers from @UK_CEH. "We need a much larger effort to move away from fossil energy and use less energy in the future."
orlo.uk/KMpGO
English
MRes BIOSI Cardiff U retweetledi

In the face of adversity, Europe is showing solidarity.
Countries, regions and cities stretching out a helping hand is what our 🇪🇺 Union is all about.
#EUsolidarity in action → europa.eu/!Ht73kF

English
MRes BIOSI Cardiff U retweetledi

Happy #WorldBeeDay 🐝
Pollinators are our life support system 💛
We can stop their decline if we all act 🦋
This is what Europeans do to protect #EUPollinators
wikis.ec.europa.eu/display/EUPKH/
With the 🆕 #EUBiodiversity & #EUFarm2Fork strategies to be announced today, we 🇪🇺 will do more!

English
MRes BIOSI Cardiff U retweetledi

Battle of the Titans! Ehm, no, #Fungi! 🍄
Aside from making for striking images, research on fungal growth traits helps us better understand #WoodDecomposition & therefore the #CarbonCycle affecting #ClimateChange!
Read our latest study in @PNASNews: bit.ly/3cxLTMj
English
MRes BIOSI Cardiff U retweetledi

If you're looking to gain new skills in how you communicate your research, take a look at our #SciComm and Public Engagement training programme. All our upcoming activities in this handy thread 👇
BES careers@BES_careers
1/9 From Zines to pitching ideas for television, our SciComm and Public Engagement training programme has something for everyone! Visit the @BritishEcolSoc training hub to see all new webinars & resources and register interest. Check this thread for more: britishecologicalsociety.org/learning-and-r…
English
MRes BIOSI Cardiff U retweetledi

EU pledges to raise €20bn a year to boost biodiversity theguardian.com/environment/20…
English
MRes BIOSI Cardiff U retweetledi

✨For 25 years, our covers have showcased the broad scope of global change’s impact on biology. To celebrate our silver anniversary, we’ve gotten a makeover. We hope you love our fresh new look as much as we do!✨ #GCBis25

English
MRes BIOSI Cardiff U retweetledi

Just got home from my first day of volunteering. Got a massive gin and tonic and a pinch on the toe! OK it’s #stagBeetle time - this is a fabulous Male @NHM_Coleoptera @Buzz_dont_tweet @WildlifeMag @BBCSpringwatch @ChrisGPackham




English
MRes BIOSI Cardiff U retweetledi

Our fortnightly series of mental health webinars continues on the 27th May, please join us tinyurl.com/yafwxf3l
English
MRes BIOSI Cardiff U retweetledi

"so many young people are adapting wonderfully to this uncertainty ... if any generation is to be congratulated for its forbearance, it is this one."
There'll be no university rites of passage this year, but students shouldn't despair | Suzanne Moore theguardian.com/commentisfree/…
English
MRes BIOSI Cardiff U retweetledi

Insects dominate global biodiversity – explore this important topic with research from the @RoyEntSoc journals for free #BiodiversityDay
onlinelibrary.wiley.com/doi/toc/10.111…

English
MRes BIOSI Cardiff U retweetledi

#EidMubarak i'm holl ffrindiau a chydweithwyr yng Nghymru ac ar draws y byd sy'n dathlu Eid al-Fitr.
#EidMubarak to all my friends and colleagues in Wales and around the world celebrating Eid al-Fitr.
CY
MRes BIOSI Cardiff U retweetledi

To mow or not to mow... why it's better to let the wildflowers grow
bbc.in/3efpFPP
English
MRes BIOSI Cardiff U retweetledi

Ganwyd Elizabeth Davis neu Betsi Cadwaladr, y nyrs a theithwraig a fu'n weinyddes yn y #Crimea, ger y #Bala, Sir Feirionnydd #arydyddhwn 1789 bywgraffiadur.cymru/article/c12-DA… #yagym #HanesCymru #Cymru

CY
MRes BIOSI Cardiff U retweetledi

Multiple methods of assessing nectar foraging conditions indicate peak foraging difficulty in late season onlinelibrary.wiley.com/doi/full/10.11…

English

